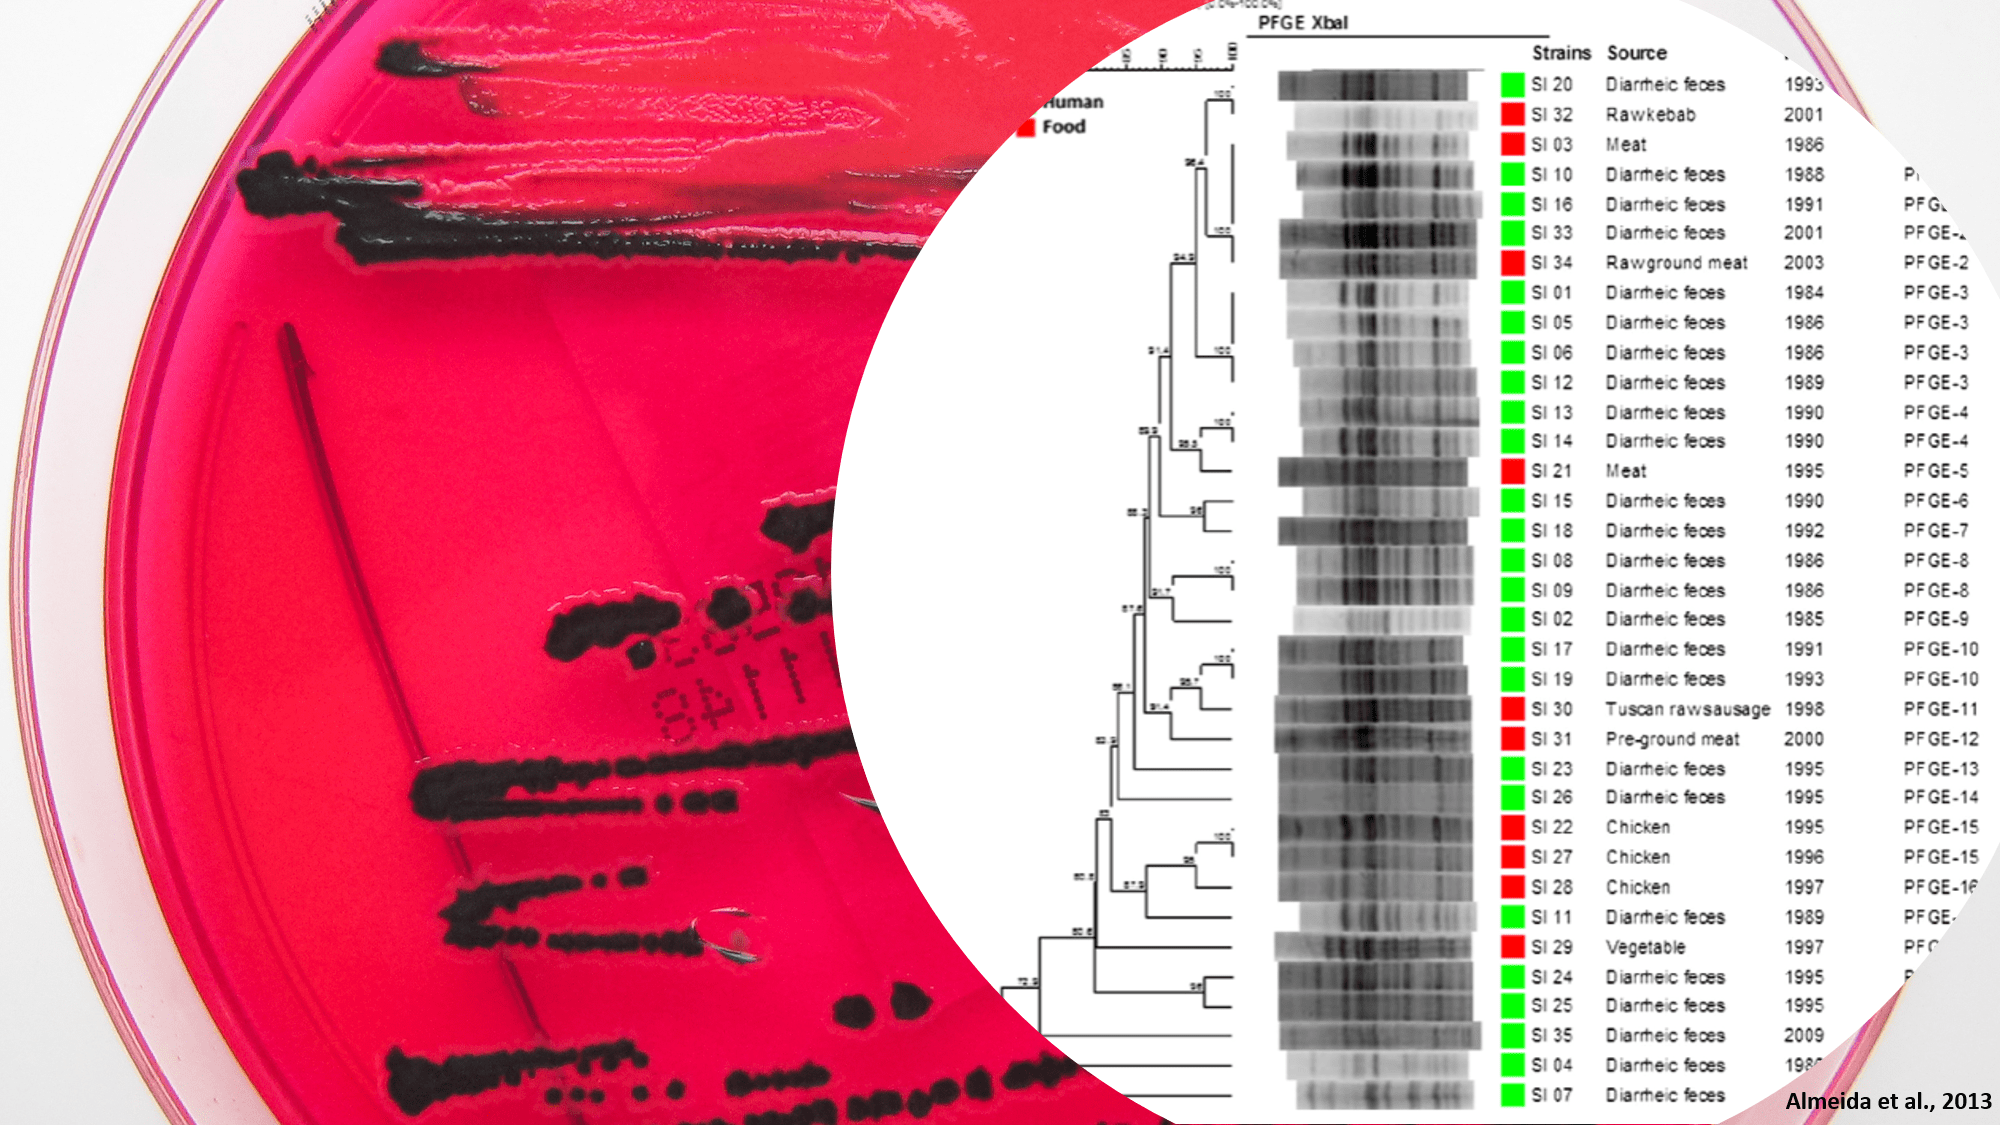
Serotipificaci%C3%B3n-min.png

28 Cursos
Métodos rápidos en microbiología de alimentos
 Organizado por: Red Interamericana de Laboratorios de Análisis de Alimentos (RILAA)
Organizado por: Red Interamericana de Laboratorios de Análisis de Alimentos (RILAA)
Disertante: Dr. Gerardo Leotta – Red de Seguridad Alimentaria CONICET
Fecha: Viernes, 5 de Mayo de 2017
Horario: 12:00 a 14:00 horas (hora RILAA)
Duración: 2 horas total
Idioma: español (sin traducción a otro idioma)
Contenidos: Introducción a los métodos rápidos en microbiología de alimentos y ambiente de producción de alimentos. Métodos rápidos para recuento de microorganismos, detección, aislamiento y caracterización de bacterias patógenas

Lineamientos Generales para la Calificación y Calibración de Instrumentos de Medición
 Organizado por: Red Interamericana de Laboratorios de Análisis de Alimentos (RILAA)
Organizado por: Red Interamericana de Laboratorios de Análisis de Alimentos (RILAA)
Disertante: Guillermo Vega Rodríguez. Coordinador de Aseguramiento de Calidad. Comisión de Control Analítico y Ampliación de Cobertura. México.
Fecha: 12 de Setiembre de 2017
Hora: Desde 15:00 hs de la RILAA
Idioma: Español (sin traducción a otro idioma)
Contenido: Tipos de calificación. Calibración de instrumentos. Calificación de equipos. Verificación metrológica de instrumentos y equipos
RILAA
Estrategia de la OPS para la contención de la resistencia antimicrobiana y para la vigilancia integrada en las Américas


Organizado por: Red Interamericana de Laboratorios de Análisis de Alimentos (RILAA).
Disertante: Dra. Simone Raszl - Centro Panamericano de Fiebre Aftosa - Panaftosa, Organización Panamericana de la Salud - OPS/OMS.
Transmisión en vivo: 22 de Noviembre de 2019, de 12:00 hs a 13:00 hs de la RILAA (UTC-2 / Etc/GMT+2). Ver hora RILAA.
Idioma: Español (sin traducción a otro idioma).
Contenido: Una de las estrategias más importantes para combatir la resistencia antimicrobiana es la implementación de un sistema de vigilancia integrado que incluya la salud humana, animal y el medio ambiente “Una salud”. La OPS en colaboración con FAO y la OIE a través de la alianza tripartita están promoviendo y fortaleciendo los sistemas de vigilancia en RAM en los países de las Américas en línea con los avances realizados en el plano de la salud. Los pilares fundamentales para una vigilancia integrada en la cadena producción de alimentos de origen animal serán discutidos en esta presentación..
RILAA
Experiencia del Centro de Referencia de Inocuidad Microbiológica de Alimentos (Costa Rica) en la utilización de la subtipificación molecular para la vigilancia de patógenos de transmisión alimentaria.

Organizado por: Red Interamericana de Laboratorios de Análisis de Alimentos (RILAA).
Disertante: Dr. Francisco Duarte Martínez.
Transmisión en vivo: 22 de Octubre de 2019, de 13:00 hs a 14:20 hs de la RILAA (UTC-2 / Etc/GMT+2). Ver hora RILAA.
Idioma: Español (sin traducción a otro idioma).
Contenido: Utilización de la subtipificación molecular para la vigilancia de patógenos de transmisión alimentaria (electroforesis en gel por campo pulsado y secuenciación de nueva generación).
RILAA
Método microbiológico para evaluar la resistencia a antimicrobianos (RAM) por difusión de sensidiscos: Experiencia de CCAYAC en el External Quality Control System (EQAS) 2018

Organizado por: Red Interamericana de Laboratorios de Análisis de Alimentos (RILAA).
Disertante: QBP Arturo Vargas Tapia
Transmisión en vivo: 18 de Octubre de 2019, de 12:00 hs a 14:00 hs de la RILAA (UTC-2 / Etc/GMT+2). Ver hora RILAA.
Idioma: Español (sin traducción a otro idioma).
Contenido: Presentación del método microbiológico de prueba de resistencia a antimicrobianos (RAM) por difusión de sensidiscos, ésta es una presentación en formato Power Point, mediante la cual se explicará a detalle el proceso analítico que se describe en las guías internacionales para aplicar la metodología. Se abordarán desde los insumos requeridos, medios de cultivo, microorganismos y reactivos necesarios. Se darán a conocer cuáles son los puntos críticos de la metodología y cuáles son las principales dificultades que como analistas se pudieran tener al momento de desarrollar la técnica, para que los laboratorios fortalezcan sus capacidades analíticas para la participación en el EQAS.
RILAA
Vigilancia integrada de la resistencia a los antimicrobianos, experiencia del Centro Nacional de Referencia de Bacteriología (Inciensa -Costa Rica)


Organizado por: Red Interamericana de Laboratorios de Análisis de Alimentos (RILAA).
Disertantes: Dra. Antonieta Jiménez Pearson y Dra. Anamariela Tijerino Ayala (Inciensa -Costa Rica)
Transmisión en vivo: 27 de Setiembre de 2019, de 13:00 hs a 14:20 hs de la RILAA (UTC-2 / Etc/GMT+2). Ver hora RILAA.
Idioma: Español (sin traducción a otro idioma).
Contenido: Vigilancia integrada de la resistencia a los antimicrobianos, experiencia del Centro Nacional de Referencia de Bacteriología (Costa Rica) .
RILAA
Introduciéndonos en la equivalencia de mediciones en el ámbito alimentario


Organizado por: Red Interamericana de Laboratorios de Análisis de Alimentos (RILAA).
Disertante: Laura Flores. MSc - Laboratorio Tecnológico del Uruguay. lflores@latu.org.uy
Transmisión en vivo: 24 de Setiembre de Setiembre de 2019, de 10:00 hs a 13:00 hs de la RILAA (UTC-2 / Etc/GMT+2). Ver hora RILAA.
Idioma: Español (sin traducción a otro idioma).
Contenido: Mediciones en laboratorios de alimentos. Tipos de métodos. Criterios de selección / diseño. Trazabilidad metrológica e incertidumbre de medición. Equivalencia entre mediciones. Herramientas de demostración de equivalencia y sus limitaciones. Criterios internacionales de comparación de métodos en el ámbito alimentario. Respuestas a las preguntas de los participantes.
RILAA
RAM, la Cadena Alimenticia y los Laboratorios de Análisis de Alimentos


Organizado por: Red Interamericana de Laboratorios de Análisis de Alimentos (RILAA).
Disertante: Prof. Armando E. Hoet, DVM, PhD, DACVPM.
Transmisión en vivo: 25 de Julio de 2019, de 13:00 hs a 14:00 hs de la RILAA (UTC-2 / Etc/GMT+2). Ver hora RILAA.
Idioma: Español (sin traducción a otro idioma).
Contenido: En el seminario se presentan las últimas investigaciones en RAM en la cadena alimenticia y el rol de los laboratorios de análisis de alimentos para la detección de cepas resistentes. Los alimentos constituyen un vector más en la transmisión de cepas resistentes que se transmiten a lo largo de la cadena agroalimentaria. Se estima que 1 de 5 infecciones en humanos son causadas por bacterias resistentes a antibióticos, provenientes de animales de granja o alimentos de origen animal. De ahí la importancia de implementar una vigilancia integrada incluyendo el sector humano, animal y alimentario. Dentro de estos programas, los laboratorios dealimentos son claves en el monitoreo y el control del problema de RAM. Ellos juegan un papel fundamental en la toma de muestra, procesamiento de la muestra, análisis y reporte.
RILAA
Consideraciones generales sobre la Resistencia Antimicrobiana


Organizado por: Red Interamericana de Laboratorios de Análisis de Alimentos (RILAA).
Disertante: Lic. Yudith Ledo Ginarte MSc. Cuba.
Transmisión en vivo: 14 de Junio de 2019, de 12:00 hs a 13:00 hs de la RILAA (UTC-2 / Etc/GMT+2). Ver hora RILAA.
Idioma: Español (sin traducción a otro idioma).
Contenido: Se abordará la definición Resistencia Antimicrobiana (RAM), la situación mundial RAM, directrices y plan de acción de la OMS, se realizará una reseña del surgimiento de los antimicrobianos y se expondrán estrategias emitidas por organizaciones internacionales para la disminución de la RAM.
RILAA
Serotipificación de Salmonella spp


Organizado por: Red Interamericana de Laboratorios de Análisis de Alimentos (RILAA).
Disertante: Arturo Vargas. Comisión de Control Analítico y Ampliación de Cobertura-Microbiología.México.
Transmisión en vivo: 09 de Julio de 2019, de 13:00 hs a 14:30 hs de la RILAA (UTC-2 / Etc/GMT+2). Ver hora RILAA.
Idioma: Español (sin traducción a otro idioma).
Contenido: Presentación del método convencional para la serotipificación de Salmonella spp con ayuda de una presentación de Power-Point, este método se aprendió del Statens Serum Institut (SSI) en Hillerod, Dinamarca y aplicando el esquema de Kauffmann & White.
RILAA
Control de la Calidad de Medios de Cultivo


Organizado por: Red Interamericana de Laboratorios de Análisis de Alimentos (RILAA).
Disertante: Dr. Claudio Rodríguez Martínez. Centro Nacional de Biopreparados. Cuba.
Transmisión en vivo: 20 y 21 de Setiembre de 2018, de 12:00 hs a 14:00 hs de la RILAA (UTC-2 / Etc/GMT+2). Ver hora RILAA.
Idioma: Español (sin traducción a otro idioma).
Contenido: Control de la calidad de medios de cultivo para análisis de alimentos según la norma ISO 11133. Respuestas a las preguntas de los participantes.
RILAA
Verificación de Cabinas de Bioseguridad


Organizado por: Red Interamericana de Laboratorios de Análisis de Alimentos (RILAA).
Disertante: Ingeniera Lilian Ríos. Departamento de Investigación, Vigilancia y Riesgo Biológico 3. Instituto Conmemorativo Gorgas de Estudios de la Salud de Panamá.
Transmisión en vivo: 11 de Setiembre de 2018, de 12:00 hs a 14:00 hs de la RILAA (UTC-2 / Etc/GMT+2). Ver hora RILAA.
Idioma: Español (sin traducción a otro idioma).
Contenido: Pruebas de campo a las que están sometidas las cabinas de bioseguridad para determinar si su funcionamiento es óptimo, de acuerdo al estándar NSF-49. Interpretación de los certificados de verificación, criterios de aceptación y rechazos de los certificados de verificación y frecuencia con que se requieren las verificaciones.
RILAA
Adaptación a la nueva norma ISO/IEC 17025:2017: cambios entre versiones y su implementación


Organizado por: Red Interamericana de Laboratorios de Análisis de Alimentos (RILAA).
Disertantes: Dra.Laura Flores, MSc del laboratorio Tecnológico del Uruguay.
Mauricio Roldán, Qco del Organismo Uruguayo de Acreditación.
Transmisión en vivo: 23 de Agosto de 2018, de 12:00 hs a 15:00 hs de la RILAA (UTC-2 / Etc/GMT+2). Ver hora RILAA.
Idioma: Español (sin traducción a otro idioma).
Contenido: Se revisarán los cambios em la estructura y requisitos de la nueva versión de la norma y se profundizará en los nuevos requisitos técnicos y de gestión, entre ellos: Objetivo y campo de aplicación. Referencias normativas. Términos y definiciones. Requisitos generales. Requisitos de estrutura. Requisitos de recursos. Requisitos de processo. Requisitos de gestión. Anexo A. Trazabilidad metrológica. Anexo B. Sistema de gestión
RILAA
Buenas Prácticas para la utilización de instrumentos volumétricos y verificación por el método gravimétrico


Organizado por: Red Interamericana de Laboratorios de Análisis de Alimentos (RILAA).
Disertante: Ing. Mauricio J. Alberini, Lab. Metrología Dimensional y Volumen, Instituto Nacional de Tecnología Industrial (INTI) Rafaela, Argentina.
Transmisiones en vivo: Jueves 30 (Parte 1) y Viernes 31 (Parte 2) de Agosto de 2018, de 12:00 a 14:00 horas (del aula virtual de la RILAA) (UTC-2 / Etc/GMT+2). Ver hora RILAA.
Idioma: Español (sin traducción a otro idioma).
Contenido: Parte 1: Selección, Utilización, Mantenimiento e Interpretación de Certificados para Instrumentos Volumétricos (matraces, pipetas, buretas, etc).
Parte 2: Selección, Utilización, Mantenimiento e Interpretación de Certificados para Instrumentos a Pistón (micropipetas, dosificadores de una entrega, dosificadores repetitivos y buretas digitales). Estimación de incertidumbre para la determinación de volumen por método gravimétrico. Respuesta a preguntas de los participantes
RILAA
Metrología: Conceptos y Trazabilidad Metrológica


Organizado por: Red Interamericana de Laboratorios de Análisis de Alimentos (RILAA).
Disertante: Msc. Soraya Sandoval Riquelme- Instituto de Salud Pública de Chile (ISP).
Transmisión en vivo: 26 de Julio de 2018, de 13:00 hs a 15:00 hs de la RILAA (UTC-2 / Etc/GMT+2). Ver hora RILAA.
Idioma: Español (sin traducción a otro idioma).
Contenido: Entregar conceptos, e introducción sobre la metrología y la trazabilidad metrológica de las mediciones realizadas por laboratorios de ensayo bajo la ISO 17025.
RILAA
Estimación de incertidumbre para métodos químicos en base a la guía Eurachem. Ejemplos prácticos.


Organizado por: Red Interamericana de Laboratorios de Análisis de Alimentos (RILAA).
Disertantes: Laura Flores, MSc - Laboratorio Tecnológico del Uruguay - lflores@latu.org.uy
Inés Álvarez Pérez - Comisión de Control Analítico y Ampliación de la Cobertura, Cofepris - ialvarez@cofepris.gob.mx
Transmisión en vivo: 26 de Junio de 2018
Horario: 13:00 hs (hora de la RILAA: UTC-2 / Etc/GMT+2) Ver hora RILAA
Idioma: Español (sin traducción a otro idioma).
RILAA
Selección, calificación y uso de termómetros y equipos de temperatura controlada


Organizado por: Red Interamericana de Laboratorios de Análisis de Alimentos.
Disertante: Ing. Hernán M. Palmero. INTI, Centro Regional Rafaela, Argentina.
Transmisión en vivo: 03 de Julio de 2018, de 11:00 hs a 13:00 hs de la RILAA (UTC-2 / Etc/GMT+2). Ver hora RILAA.
Idioma: Español (sin traducción a otro idioma).
Contenido: Selección de termómetros y equipos de temperatura controlada (estufas, incubadoras, baños termostáticos, heladeras y autoclaves). Calibración/ensayo y controles intermedios. Intervalos de calibración y confirmación metrológica. Interpretación de certificados de calibración e informes de ensayo. Respuesta a preguntas realizadas por los participantes.
.
RILAA
Evaluación de desempeño de medios de cultivo con base en la ISO 11133:2015
 Organizado por: Red Interamericana de Laboratorios de Análisis de Alimentos (RILAA).
Organizado por: Red Interamericana de Laboratorios de Análisis de Alimentos (RILAA).
Disertante: QBP Fabiola Castañeda Lopez - Coordinadora de Medios de Cultivo. Gerencia de Análisis y Desarrollo de Pruebas Microbiológicas. COMISIÓN DE CONTROL ANALÍTICO Y AMPLIACIÓN DE COBERTURA, MÉXICO.
Transmisión en vivo: 25 de Mayo de 2018, de 13:00 hs a 14:30 hs de la RILAA (UTC-2 / Etc/GMT+2). Ver hora RILAA.
Idioma: Español (sin traducción a otro idioma).
Contenido: Presentación del contenido de la norma y exposición de la experiencia en la implementación de la norma en la rutina.
RILAA
Selección, puesta en servicio y calificación de instrumentos de pesar (balanzas y pesas) en laboratorios de microbiología de alimentos
 Organizado por: Red Interamericana de Laboratorios de Análisis de Alimentos (RILAA).
Organizado por: Red Interamericana de Laboratorios de Análisis de Alimentos (RILAA).
Disertante: Técnico Marcelo C. Fuentes. INTI-Mar del Plata. Argentina.
Transmisión en vivo: 31 de Mayo de 2018, de 12:00 hs a 14:00 hs de la RILAA (UTC-2 / Etc/GMT+2). Ver hora RILAA.
Idioma: Español (sin traducción a otro idioma).
Contenido: Claves para la selección de equipos, instalaciones, calibración y controles intermedios, evaluación de certificados de calibración.Relación del instrumento con las normas a implementar.
RILAA
Las colecciones microbianas internacionales. Conservación a corto, mediano y largo plazo. Bioética y Bioseguridad.
 Organizado por: Red Interamericana de Laboratorios de Análisis de Alimentos (RILAA).
Organizado por: Red Interamericana de Laboratorios de Análisis de Alimentos (RILAA).
Disertante: Dra. Graciela Castro Escarpulli, Red de Salud IPN, México.
Transmisión en vivo: 22 de Marzo de 2018, de 14:00 hs a 16:00 hs de la RILAA (UTC-2 / Etc/GMT+2). Ver hora RILAA.
Idioma: Español (sin traducción a otro idioma).
Contenido: Introducción a los métodos de conservación bacteriana. Los microorganismos juegan un papel destacado en áreas diversas de la biología; por lo que su aislamiento, caracterización y conservación son muy importantes. Objetivo. Lograr establecer una colección. de cultivos microbianos es requisito indispensable para tener un acervo de la biodiversidad microbiana existente y proporcionar elementos útiles en la estandarización de métodos y validación de productos para ensayos diversos. Las colecciones de microorganismos ofrecen materia prima para estudios moleculares y en biotecnología.